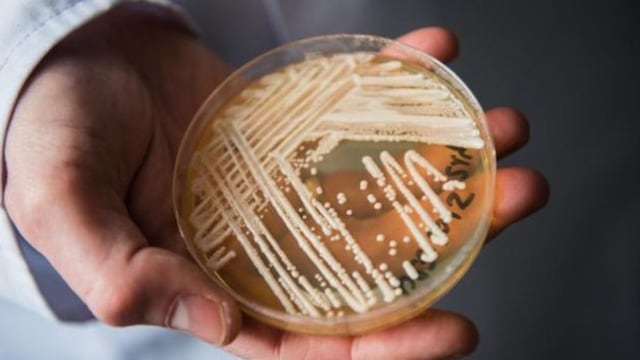
Ya es el tercer caso que se registra del "Súper Hongo" en Brasil.

Dante, un niño de dos años, sufre “Aniridia”, una enfermedad que le dificulta ver la luz, y necesita ayuda para poder comprar el par de lentes que le permite mejorar la calidad de su vista.
En diálogo con “0221.com.ar”, Rocío, la madre del menor contó que “se lo diagnosticaron durante un control cuando tenía dos meses”, y desde ese momento hacen todo lo posible para que Dante pueda contar con los lentes de contacto especiales que duran un año. “Vendimos todo para comprarle el primer par de lentes”, agregó.

Sin embargo, los mismos cuestan 246.300 pesos, un monto difícil de afrontar para la familia. “Si no tiene eso, se le dificulta ver. Lo necesita para poder seguir estimulándose como un nene normal”, se lamentó su madre. Por esta razón, su madre pidió ayuda a través de las redes sociales, en donde publicó los datos de su cuenta bancaria para poder donar. “Hasta el momento juntamos 3.500 pesos”, contó Rocío.
Cómo contribuir con Dante:
CBU: 0720743588000040087340
Alias: TRUENO.TIZA.JEFA
Contacto: 2215414332
Qué es la enfermedad de Aniridia
La aniridia es una patología que se caracteriza por la ausencia total o parcial del iris, el anillo coloreado que rodea la pupila y que, además de dar color a nuestros ojos, regula la cantidad de luz que entra en el globo ocular. Puede ser ocasionada por un traumatismo, cirugía complicada o un defecto genético.